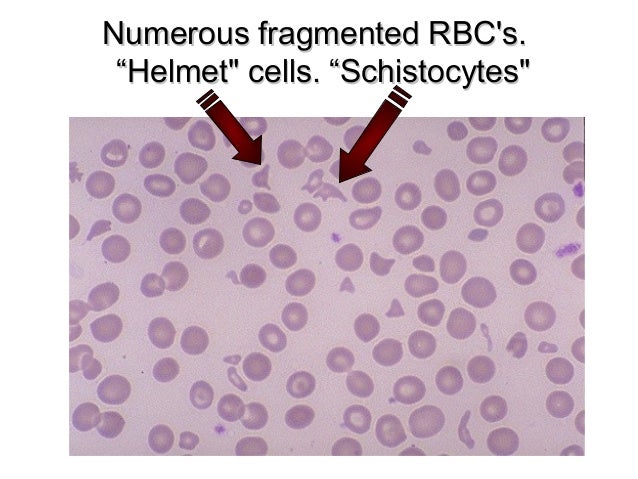
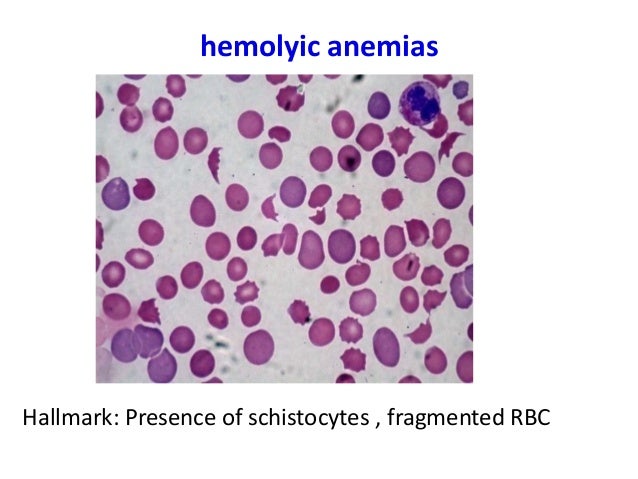

Fragmented Rbc Images

Morphology Of Rcb In Health And Disease Hematology Cls 531 Prepared By Hajar Alqadeeb Ppt Download

Detail View Sysmex

Fatal Microangiopathic Hemolytic Anemia Two Case Reports Basit Momin Ma Prusty Sk Aluri A Soumya V J Sci Soc
Http Vet Sagepub Com Content 18 4 415 Full Pdf

S3b5 Pom Microangiopathic Hemolytic Anemia Flashcards Quizlet
Onlinelibrary Wiley Com Doi Pdf 10 1111 J 1751 553x 11 X


Schistocytes Helmet Cells And Polychromasia
3

Morphological Abnormalities Of Red Blood Cells The Art Of Medicine

Red Blood Cell Rbc Part 1 Peripheral Blood Smear Normal Picture And Rbc Morphology Labpedia Net
Helmet Helmet Cells Rbc

Red Blood Cell Inclusions And Abnormalities Hematology

Polychromasia What It Is Causes Symptoms Treatment

Platelets

Red Blood Cell Membrane Fragments But Not Intact Red Blood Cells Promote Calcium Oxalate Monohydrate Crystal Growth And Aggregation Sciencedirect

Rbc Abnormalities Flashcards Quizlet
Pathlogos Schistiocyte Are Fragmented Rbc Due To Facebook

Schistocytes Aka Helmet Cells Fragmented Rbc S Seen In Dic Hus Ttp And Mechanical Rbc Destr Hematology Medical Technology Medical Laboratory Science

Morphological Abnormalities Of Red Blood Cells The Art Of Medicine

Schistocytes Schistocytes Are Fragmented Red Blood Cells A That Result From Mechanical Damage To Red Cells As They Circulate In The Blood This Damage May Occur When Red Cells Pass Through Fibrin Strands Of Clots As In Disseminated Intravascular

Morphological Abnormalities Of Red Blood Cells The Art Of Medicine

Figure 2 From Association Of Graves Disease With Evans Syndrome In A Patient With Iga Nephropathy Semantic Scholar
Applications Of The Blood Smear In Emergency Medicine Wsava02 Vin

Normal Rbc 7 Micron Diameter Round To Slight Oval Biconcave Disk 1 3 Central Pallor Ppt Video Online Download

Schistocyte Wikipedia

Red Blood Cells Disorders Ppt Download

Helmet Helmet Cells Rbc

Fragmented Rbcs Schistocytes Download Scientific Diagram

Hematologyoutlines Atlas

July 25 15 Microangiopathic Hemolytic Anemia And Thrombocytopenia Answers The Asco Post

Fragmented Red Blood Cells Frc

Complete Blood Count Cbc Part 2 Red Blood Cells Morphology And Interpretation Labpedia Net

Lab Evaluation Of Schistocytes Elite Learning

Patient S Peripheral Blood Smear Showing Fragmented Red Blood Cells Download Scientific Diagram

Hematologyoutlines Atlas

Schistocytes Actual Fragmented Rbcs Hematology Medical Laboratory Medical Laboratory Technician

Fragmentation Erythroidee

شیستوسیت ویکی پدیا دانشنامه آزاد
Http Www Cap Org Apps Docs Committees Hematology Hematology Discussion 12 Vpbs A Pdf

Red Blood Cell Inclusions And Abnormalities Hematology

Peripheral Blood Smear Shows Spherocytes Fragmented Rbc Nucleated Download Scientific Diagram

Abnormal Rbc Morphology Flashcards Quizlet

Helmet Helmet Cells Rbc

A Case Of Subacute Onset Myelodysplastic Syndrome With Infection Mimicking Thrombotic Thrombocytopenic Purpura A Case Report With Literature Review Renal Replacement Therapy Full Text

Red Blood Cell Inclusions And Abnormalities Hematology
3
Http Www Cap Org Apps Docs Committees Hematology Hematology Discussion 12 Vpbs A Pdf

Fragmented Red Blood Cell Or Schistocyte Medical Laboratories

05 Peripheral Blood Smear Examination

Red Blood Cell Membrane Fragments But Not Intact Red Blood Cells Promote Calcium Oxalate Monohydrate Crystal Growth And Aggregation Sciencedirect

Fragmented Rbcs Schistocytes Medical

Morphological Abnormalities Of Red Blood Cells The Art Of Medicine

Red Blood Cell Rbc Part 1 Peripheral Blood Smear Normal Picture And Rbc Morphology Labpedia Net

Fragmented Red Blood Cells Frc
Q Tbn And9gct5ehbeoope6bxj0enmvexfgblccmiycwqkthmuois Usqp Cau

Red Blood Cells Disorders Pptx د علي محمد جواد Muhadharaty

What S A Schistocyte Aka Helmet Cell Or Fragmented Cell Youtube

The Spectrum Of Red Blood Cell Parameters In Chronic Kidney Disease A Study Of 300 Cases Shastry I Belurkar S J Appl Hematol
Http Www Cap Org Apps Docs Committees Hematology Hematology Discussion 12 Vpbs A Pdf

Fragmented Rbcs Schistocytes Medical

Image Schistocytes Red Blood Cell Fragments Msd Manual Professional Edition
Academic Oup Com Labmed Article Pdf 35 2 98 Labmed35 0098 Pdf

Medpics Uc San Diego School Of Medicine

Google Image Result For Http Www Wadsworth Org Chemheme Heme Glass Cytopix Sl Hematology Medical Laboratory Animal Medicine

Peripheral Blood Smear Showing Fragmented Red Blood Cells Rbcs Download Scientific Diagram

Morphology Of Red Blood Cells
Q Tbn And9gcszoeb3y18ravshnjeh4flfardlgjk84vucofmakvwxvd Cgitm Usqp Cau

Hematopathology

Lab Evaluation Of Schistocytes Elite Learning

Does Morphology Matter In 17 An Approach To Morphologic Clues In Non Neoplastic Blood And Bone Marrow Disorders Chabot Richards 17 International Journal Of Laboratory Hematology Wiley Online Library
Http Www Cap Org Apps Docs Committees Hematology Hematology Discussion 12 Vpbs A Pdf

Hemostasis Pt 1 Flashcards Quizlet
05 Peripheral Blood Smear Examination

Peripheral Blood Smears Veterian Key

Peripheral Blood Smear Shows Spherocytes Fragmented Rbc Nucleated Download Scientific Diagram

اسامة صفدر Typical Fragmented Rbc Schizocye In Hemolytic Uremic Syndrome Med12 T Co Wa6hhkqawf

Schistocytes On The Peripheral Blood Smear Mayo Clinic Proceedings

Red Blood Cell Morphology Ppt Download

Red Blood Cell Inclusions And Abnormalities Hematology

Icsh Recommendations For Identification Diagnostic Value And Quantitation Of Schistocytes Zini 12 International Journal Of Laboratory Hematology Wiley Online Library

Microangiopathic Hemolytic Anemia Cancer Therapy Advisor

Icsh Recommendations For Identification Diagnostic Value And Quantitation Of Schistocytes Zini 12 International Journal Of Laboratory Hematology Wiley Online Library

Icsh Recommendations For Identification Diagnostic Value And Quantitation Of Schistocytes Zini 12 International Journal Of Laboratory Hematology Wiley Online Library
Red Blood Cell Destruction In Autoimmune Hemolytic Anemia Role Of Complement And Potential New Targets For Therapy

Shape Changes Eclinpath

Fatal Microangiopathic Hemolytic Anemia Two Case Reports Basit Momin Ma Prusty Sk Aluri A Soumya V J Sci Soc

Helmet Helmet Cells Rbc

Red Blood Cell Inclusions And Abnormalities Hematology

Pseudo Thrombotic Thrombocytopenic Purpura A Rare Presentation Of Pernicious Anemia

Helmet Helmet Cells Rbc

Blood Film Showing Microangiopathic Hemolytic Anemia With Download Scientific Diagram

The Spectrum Of Red Blood Cell Parameters In Chronic Kidney Disease A Study Of 300 Cases Shastry I Belurkar S J Appl Hematol

Rbc Morphology And Cases Ppt Video Online Download

Hematologyoutlines Atlas

Morphology Of Red Blood Cells

Helmet Helmet Cells Rbc

Pseudo Thrombotic Thrombocytopenic Purpura A Rare Presentation Of Pernicious Anemia

Pin On Rbc Variations

Haematology Thrombotic Thrombocytopenic Purpura Gponline
Red Cell Fragments Can Mask Severe Thrombocytopenia

Hematologyoutlines Atlas
Stock Image Photomicrograph Of Schistocytosis Hemolytic Anemia In A Blood Smear Also Known As Schizocytosis This Is The Presenceof Many Fragmented Red Blood Cells Schistocytes Which Re Sults In Anemia C Prof

Red Blood Cell Rbc Part 1 Peripheral Blood Smear Normal Picture And Rbc Morphology Labpedia Net

Post Traumatic Thrombotic Microangiopathy Following Pelvic Fracture Treated With Transcatheter Arterial Embolization A Case Report Springerlink